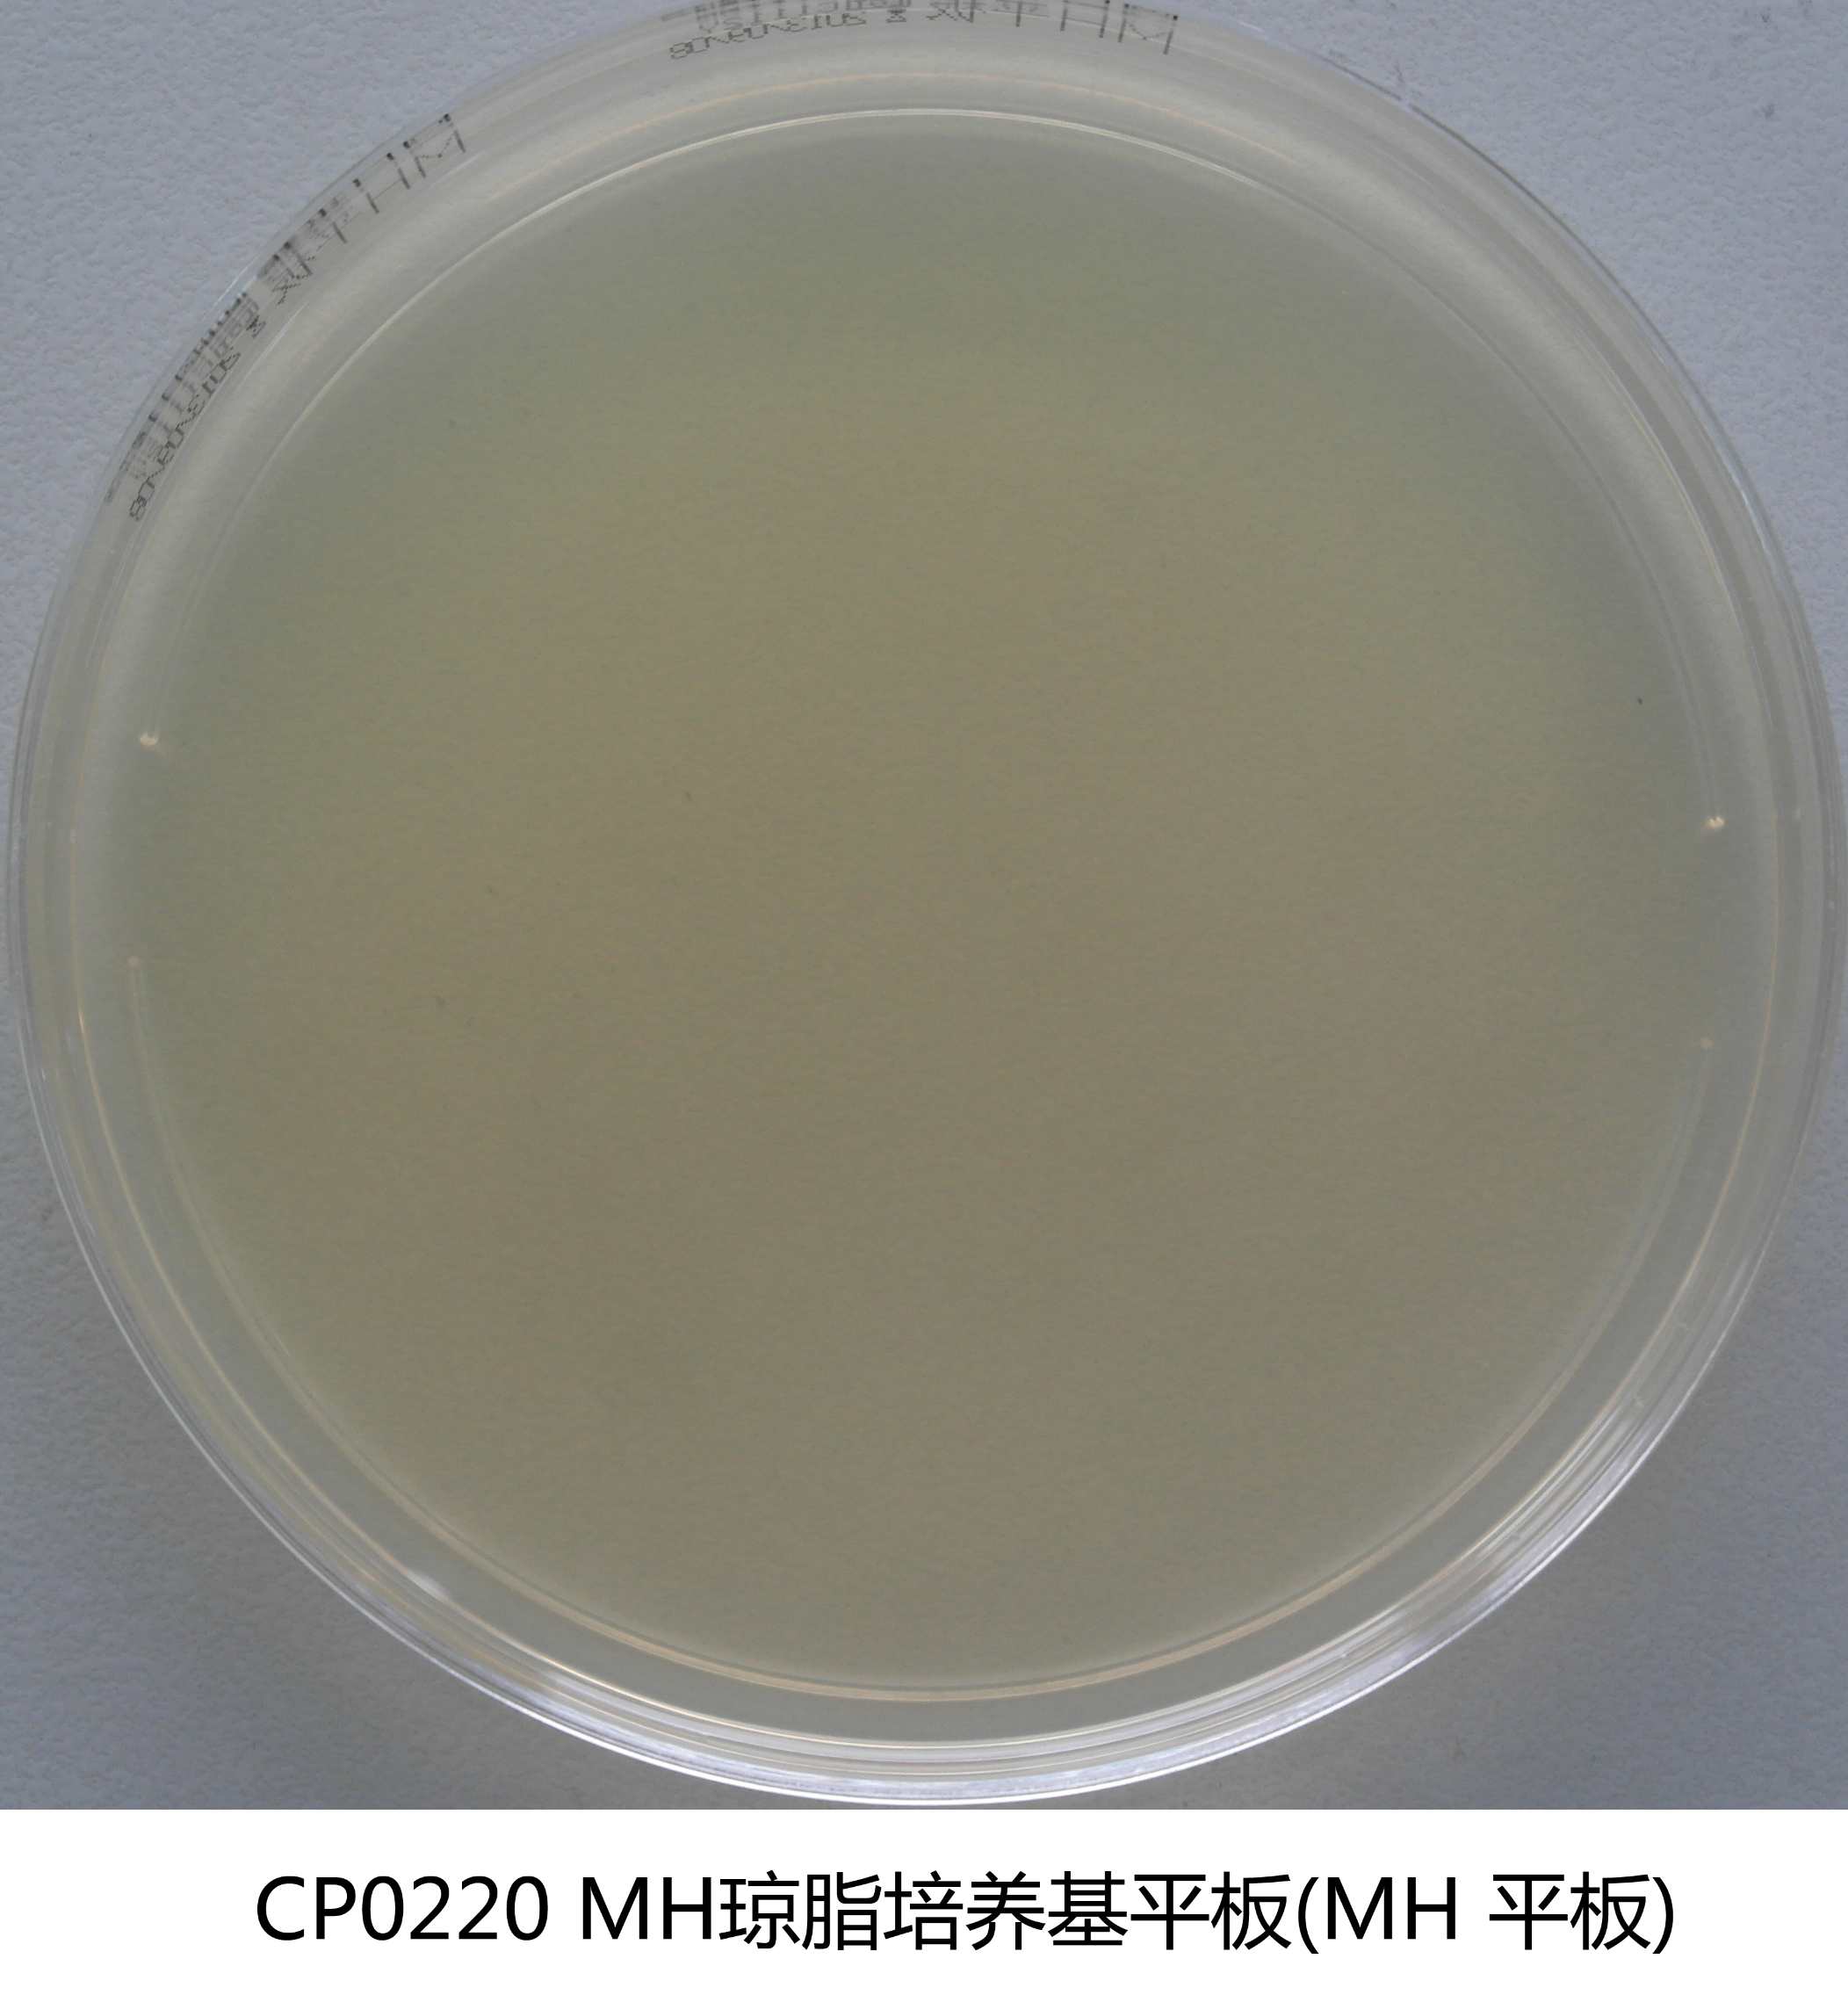
MH瓊脂平板培養(yǎng)基 MH瓊脂平板培養(yǎng)基

商品詳細(xì)
行業(yè)應(yīng)用
相關(guān)論文
說明書
培訓(xùn)資料
相關(guān)視頻
產(chǎn)品名稱:MH瓊脂平板
英文名稱:Mueller Hinton Agar (Plate)
產(chǎn)品編號(hào)與包裝規(guī)格:
| 產(chǎn)品編號(hào) | 產(chǎn)品類型 | 包裝規(guī)格 |
|---|---|---|
| CP0220 | 即用型成品平板 | 90mm×20個(gè)/盒 |
產(chǎn)品用途:用于藥敏試驗(yàn)瓊脂稀釋法及擴(kuò)散法。
檢驗(yàn)原理:牛肉浸出粉和酸水解酪蛋白提供氮源、維生素和氨基酸;可溶性淀粉吸收有毒的代謝產(chǎn)物;瓊脂是培養(yǎng)基的凝固劑。
MH瓊脂平板培養(yǎng)基配方成分:
| 配方(每升) | 含量 |
|---|---|
| 牛肉浸粉 | 2.0g |
| 可溶性淀粉 | 1.5g |
| 酸水解酪蛋白 | 17.5g |
| 瓊脂粉 | 17.0g |
| 蒸餾水 | 1000mL |
| 最終pH 7.4±0.2 | |
使用方法:拆開包裝即可使用。
質(zhì)量控制:質(zhì)控標(biāo)準(zhǔn)具體參照質(zhì)檢報(bào)告
儲(chǔ)存條件與保質(zhì)期:2-25℃避光保存,有效期見產(chǎn)品標(biāo)簽。
注意事項(xiàng):MH瓊脂平板培養(yǎng)基(一次性平板培養(yǎng)基)置于冰箱冷藏保存需與存放容器冷凝管保持一定距離以避免凍損壞。產(chǎn)品多次在低溫與常溫之間變更會(huì)引起瓊脂的泌水,屬于正常現(xiàn)象。使用前應(yīng)平衡至室溫且盡量在無菌干燥箱中預(yù)干燥。
參考文獻(xiàn):
1、《中華人民共和國藥典》2010年版
2、《實(shí)用醫(yī)學(xué)培養(yǎng)基手冊》
3、YY/T 0665-2008 MH瓊脂培養(yǎng)基
本產(chǎn)品僅限于科研研究用途,不能用于醫(yī)院和臨床檢測,購買者請知悉!
